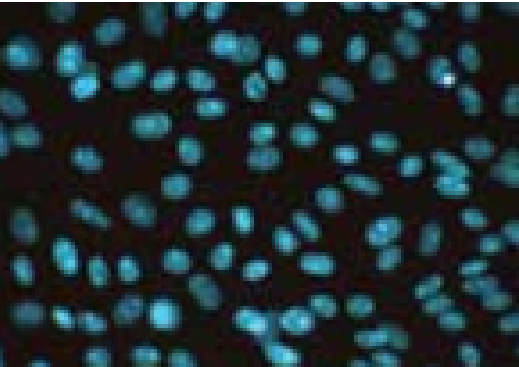
小鼠胚胎成纤维细胞(来自NIH3T3)_PA12

相关产品推荐更多 >
万千商家帮你免费找货
0 人在求购买到急需产品
- 详细信息
- 技术资料
- 库存:
100
- 细胞类型:
科研
- 品系:
详情请咨询我司客服
- 组织来源:
详情请咨询我司客服
- 物种来源:
鼠/人/其它
- 细胞形态:
上皮样/成纤维样/其它
- 器官来源:
详情请咨询我司客服
- 运输方式:
常温运输/干冰运输
- 年限:
详情请咨询我司客服
- 生长状态:
贴壁/悬浮
- 英文名:
PA12
小鼠胚胎成纤维细胞(来自NIH3T3)_PA12购买须知:
产品简介:
[品系] ……………………Human
[组织来源]………………详情请咨询
[生长状态]………………贴壁/悬浮
[细胞类型]………………详情请咨询
[疾病] ……………………正常
[应用] ……………………科研
生物安全:
不含有 HIV-1、 HBV、HCV、支原体、细菌、酵母和真菌等。
产品包装:
提供新鲜或者冻存的细胞
使用方法:
如是新鲜细胞,客户收到细胞后应立即将其放入CO2细胞培养箱内静置3-4个小时,再进行后续的实验操作;如是冻存细胞, 客户收到细胞后应立即将其放入液氮、-80℃冰箱或立即进行复苏。
细胞培养 :
(1) 从ATCC细胞系开始:
ATCC细胞系和杂交瘤在冻存小瓶或生长的冰上运输。在环境温度下烧瓶中的培养物。一收到冷冻细胞,重要的是立即恢复。他们通过解冻和去除二甲基亚砜,并将它们放入培养基中。如果这是不可能的,请存储液氮蒸气中的细胞(在130°C以下)。不要在130℃以上的温度下储存冷冻细胞。它们的生存能力将迅速下降。
(2)细胞图片:

(3)启动冷冻培养:
1。准备一个培养容器,使其含有推荐的体积。在产品表上列出的适当培养基中,平衡温度和pH(Co)。
2。在37℃的水浴或该细胞的正常生长温度下用温和搅拌使小瓶融化。线。解冻应该很快,大约2分钟,或者直到冰晶融化。
3. 从水浴中取出小瓶,浸泡或喷洒70%乙醇去污。 遵循严格无菌条件在层流组织培养罩,所有进一步的操作。
4. 拧开瓶顶并将其转移到无菌中。离心管含有9毫升推荐的培养基。用温和离心法去除冷冻保护剂(DMSO)(10)125×g分钟。弃上清液,复苏细胞在1或2毫升完全生长培养基中。转移细胞悬液进入含有完整生长培养基的培养容器中轻轻摇晃搅拌均匀。
5. 24小时后检查细胞培养物并根据需要进行传代培养。
(4) 培养瓶培养:
一些ATCC细胞在培养容器中作为生长培养物运输。这些容器接种有细胞,孵育以确保细胞生长,然后完全填满培养基用于运输。在接收烧瓶培养物时,目视检查培养基以获得微生物污染的宏观证据。这包括不寻常的pH变化(黄色或紫色的酚红)浊度,或颗粒。低功率倒置显微镜(100×)检验微生物污染的培养基以及细胞形态。详情请参阅检查细胞培养物
(5) 如果细胞附着并生长在单层:
1。无菌去除所有5毫升至10毫升的海运培养基。可以节省运输介质以重复使用。应存放在4°C。
2。在产品板上推荐温度和CO浓度的培养瓶(37°C,大多数细胞系有5%个Co)直到细胞继代培养。
(6) 如果细胞没有附着或生长在悬浮液中:
1。无菌地将烧瓶的整个内容转移到离心机管上。
2。离心125×5~10分钟。
3。除去所有的,但10毫升的运输介质上清液和复苏细胞。余数存储这种介质在4°C以后使用。
4。根据细胞将无菌细胞无菌转移到25厘米的烧瓶或75厘米的烧瓶中。行(见产品表)。
5。在温度和CO浓度下培养细胞以推荐产品信息直到细胞被传代培养。
大多数细胞系起始于源自一块被切碎或酶分散的组织的原代培养物。
经过一段时间后,初级培养物将达到融合状态,此时的所有可用空间培养皿由于细胞膨胀而被覆盖。在这一点上,文化需要被分解。(通常用胰蛋白酶等蛋白水解酶)进入单个细胞和传代培养(分裂,传代,或转让。继第一次传代后,培养一般称为细胞系。与每个继代培养后,细胞群变得比生长较快的细胞更均匀。占主导地位。具有所需特性的细胞也可以通过克隆从培养物中选出。
二倍体细胞系很少进展超过少数群体倍增。它们具有有限的复制容量。在20到80次人口倍增后开始减速并最终停止分裂。提示在细胞培养中观察到的一些细胞衰老可能是由于不适当的培养引起的。与预定复制衰老相对应的条件。还有其他数据支持复制某些物种(特别是人)的细胞衰老,即使在改良的培养条件下生长。这种衰老是由染色体末端(端粒)与每个细胞的缩短所介导的。原代培养,作为几种细胞类型的混合物,保留其源组织的特征。
质量可靠,售后有保障
如运输过程中导致细胞污染或者死亡,我们将无条件补发收货后十个工作日内有其他问题提供照片可半价重发
小鼠胚胎成纤维细胞(来自NIH3T3)_PA12相关产品:
产品简介:
[品系] ……………………Human
[组织来源]………………详情请咨询
[生长状态]………………贴壁/悬浮
[细胞类型]………………详情请咨询
[疾病] ……………………正常
[应用] ……………………科研
生物安全:
不含有 HIV-1、 HBV、HCV、支原体、细菌、酵母和真菌等。
产品包装:
提供新鲜或者冻存的细胞
使用方法:
如是新鲜细胞,客户收到细胞后应立即将其放入CO2细胞培养箱内静置3-4个小时,再进行后续的实验操作;如是冻存细胞, 客户收到细胞后应立即将其放入液氮、-80℃冰箱或立即进行复苏。
细胞培养 :
(1) 从ATCC细胞系开始:
ATCC细胞系和杂交瘤在冻存小瓶或生长的冰上运输。在环境温度下烧瓶中的培养物。一收到冷冻细胞,重要的是立即恢复。他们通过解冻和去除二甲基亚砜,并将它们放入培养基中。如果这是不可能的,请存储液氮蒸气中的细胞(在130°C以下)。不要在130℃以上的温度下储存冷冻细胞。它们的生存能力将迅速下降。
(2)细胞图片:
(3)启动冷冻培养:
1。准备一个培养容器,使其含有推荐的体积。在产品表上列出的适当培养基中,平衡温度和pH(Co)。
2。在37℃的水浴或该细胞的正常生长温度下用温和搅拌使小瓶融化。线。解冻应该很快,大约2分钟,或者直到冰晶融化。
3. 从水浴中取出小瓶,浸泡或喷洒70%乙醇去污。 遵循严格无菌条件在层流组织培养罩,所有进一步的操作。
4. 拧开瓶顶并将其转移到无菌中。离心管含有9毫升推荐的培养基。用温和离心法去除冷冻保护剂(DMSO)(10)125×g分钟。弃上清液,复苏细胞在1或2毫升完全生长培养基中。转移细胞悬液进入含有完整生长培养基的培养容器中轻轻摇晃搅拌均匀。
5. 24小时后检查细胞培养物并根据需要进行传代培养。
(4) 培养瓶培养:
一些ATCC细胞在培养容器中作为生长培养物运输。这些容器接种有细胞,孵育以确保细胞生长,然后完全填满培养基用于运输。在接收烧瓶培养物时,目视检查培养基以获得微生物污染的宏观证据。这包括不寻常的pH变化(黄色或紫色的酚红)浊度,或颗粒。低功率倒置显微镜(100×)检验微生物污染的培养基以及细胞形态。详情请参阅检查细胞培养物
(5) 如果细胞附着并生长在单层:
1。无菌去除所有5毫升至10毫升的海运培养基。可以节省运输介质以重复使用。应存放在4°C。
2。在产品板上推荐温度和CO浓度的培养瓶(37°C,大多数细胞系有5%个Co)直到细胞继代培养。
(6) 如果细胞没有附着或生长在悬浮液中:
1。无菌地将烧瓶的整个内容转移到离心机管上。
2。离心125×5~10分钟。
3。除去所有的,但10毫升的运输介质上清液和复苏细胞。余数存储这种介质在4°C以后使用。
4。根据细胞将无菌细胞无菌转移到25厘米的烧瓶或75厘米的烧瓶中。行(见产品表)。
5。在温度和CO浓度下培养细胞以推荐产品信息直到细胞被传代培养。
大多数细胞系起始于源自一块被切碎或酶分散的组织的原代培养物。
经过一段时间后,初级培养物将达到融合状态,此时的所有可用空间培养皿由于细胞膨胀而被覆盖。在这一点上,文化需要被分解。(通常用胰蛋白酶等蛋白水解酶)进入单个细胞和传代培养(分裂,传代,或转让。继第一次传代后,培养一般称为细胞系。与每个继代培养后,细胞群变得比生长较快的细胞更均匀。占主导地位。具有所需特性的细胞也可以通过克隆从培养物中选出。
二倍体细胞系很少进展超过少数群体倍增。它们具有有限的复制容量。在20到80次人口倍增后开始减速并最终停止分裂。提示在细胞培养中观察到的一些细胞衰老可能是由于不适当的培养引起的。与预定复制衰老相对应的条件。还有其他数据支持复制某些物种(特别是人)的细胞衰老,即使在改良的培养条件下生长。这种衰老是由染色体末端(端粒)与每个细胞的缩短所介导的。原代培养,作为几种细胞类型的混合物,保留其源组织的特征。
质量可靠,售后有保障
如运输过程中导致细胞污染或者死亡,我们将无条件补发收货后十个工作日内有其他问题提供照片可半价重发
小鼠胚胎成纤维细胞(来自NIH3T3)_PA12相关产品:
| 3T6-Swiss albino(胚胎成纤维细胞) |
| PA317(成纤维细胞) |
| 3T3-Swiss albino(胚胎成纤维细胞) |
| Mo-MuLv/3T3(Mo-MuLv感染的3T3细胞) |
| MRC-5(胚肺细胞) |
| WI-38(胚肺细胞) |
| FRhK-4(恒河猴胚肾细胞) |
| VERO C1008 (E6)(非洲绿猴肾细胞) |
| Pt K1 (NBL-3)(长鼻袋鼠肾细胞) |
| L1210(白血病细胞) |
| Neuro-2A(脑神经瘤细胞) |
| PC-12(肾上腺嗜铬细胞瘤细胞) |
| HeLa(宫颈癌细胞) |
| A549 [A-549](肺癌细胞) |
| MCF7(乳腺癌细胞) |
| Hep 3B2.1-7(肝癌细胞) |
| MDA-MB-231(乳腺癌细胞) |
| Hep G2(肝癌细胞) |
| HCT 116(结肠癌细胞) |
| 22RV1(前列腺癌细胞) |
| HT-29(结肠癌细胞) |
| KG-1(白血病细胞) |
| LoVo(结肠癌细胞) |
| THP-1(单核细胞白血病) |
| SW620(结肠癌细胞) |
| SK-N-SH(神经母细胞瘤细胞) |
| SH-SY5Y(神经母细胞瘤细胞) |
风险提示:丁香通仅作为第三方平台,为商家信息发布提供平台空间。用户咨询产品时请注意保护个人信息及财产安全,合理判断,谨慎选购商品,商家和用户对交易行为负责。对于医疗器械类产品,请先查证核实企业经营资质和医疗器械产品注册证情况。
技术资料暂无技术资料 索取技术资料
小鼠胚胎成纤维细胞(来自NIH3T3)_PA12
¥600 - 2000









